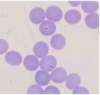

Blood pressure = ___ x ___
CO x vascular resistance
What are pressure overload diseases?
A. Diseases that result in reduced relaxation function of the heart
B. Diseases that require the heart to generate greater than normal ventricular pressures to eject blood
C. Diseases that result in reduced pumping function of the heart (low SV and CO)
D. Diseases that result in a higher than normal end diastolic volume in the ventricle
B. Diseases that require the heart to generate greater than normal ventricular pressures to eject blood
What are volume overload diseases?
A. Diseases that result in reduced relaxation function of the heart
B. Diseases that require the heart to generate greater than normal ventricular pressures to eject blood
C. Diseases that result in reduced pumping function of the heart (low SV and CO)
D. Diseases that result in a higher than normal end diastolic volume in the ventricle
D. Diseases that result in a higher than normal end diastolic volume in the ventricle
What are systolic dysfunction diseases?
A. Diseases that result in reduced relaxation function of the heart
B. Diseases that require the heart to generate greater than normal ventricular pressures to eject blood
C. Diseases that result in reduced pumping function of the heart (low SV and CO)
D. Diseases that result in a higher than normal end diastolic volume in the ventricle
C. Diseases that result in reduced pumping function of the heart (low SV and CO)
What are diastolic dysfunction diseases?
A. Diseases that result in reduced relaxation function of the heart
B. Diseases that require the heart to generate greater than normal ventricular pressures to eject blood
C. Diseases that result in reduced pumping function of the heart (low SV and CO)
D. Diseases that result in a higher than normal end diastolic volume in the ventricle
A. Diseases that result in reduced relaxation function of the heart
Which murmur descriptor DOES NOT help you to determine the source of the murmur?
A. Grade
B. Point of maximal intensity (PMI) location
C. Timing
D. Quality
A. Grade
What is the clinical cause for jugular pulsation?
A) Turbulent blood flow at the pulmonic or aortic valve
B) Turbulent blood flow at the mitral valve
C) Elevated right heart pressures
D) Reduced SV
C. Elevated right heart pressures
What is the cause for a murmur with a PMI at the left base?
A) Turbulent blood flow at the pulmonic or aortic valve
B) Turbulent blood flow at the mitral valve
C) Elevated right heart pressures
D) Reduced SV
A. Turbulent blood flow at the pulmonic or aortic valve.
What is the cause for a murmur with a PMI at the left apex?
A) Turbulent blood flow at the pulmonic or aortic valve
B) Turbulent blood flow at the mitral valve
C) Elevated right heart pressures
D) Reduced SV
B. Turbulent blood flow at the mitral valve.
What is the cause for hypokinetic femoral pulses?
A) Turbulent blood flow at the pulmonic or aortic valve
B) Turbulent blood flow at the mitral valve
C) Elevated right heart pressures
D) Reduced SV
D. Reduced SV
What are the 3 radiographic hallmarks of left-sided CHF?
- Moderate to severe LA dilation
- Pulmonary venous dilation
- Interstitial to alveolar pattern
What are the 3 radiographic hallmarks of right-sided CHF?
- Moderate to severe right heart enlargement
- Dilated caudal vena cava
- Effusion (e.g. pleural effusion)
What type of descriptive information is used to stage heart disease patients using the ACVIM classification system?
Structural depiction of what the heart looks like
You have an 8 year old FS mixed breed dog with mitral valve disease and moderate left atrial enlargement on an echocardiogram.
Stage the heart disease using the ACVIM staging system.
Stage B2
What is the definition of heart failure?
The heart pumping an inadequate volume of blood to meet the O2 demands of tissue despite normal to high venous return.
The presence of fluid accumulation in the form of pulmonary edema, pleural effusion, ascites/hepatomegaly, pericardial effusion, and/or peripheral edema are clinical signs of ___ heart failure.
backward (congestive)
Which of the following alterations will help to treat a patient with heart failure?
A) Increase inotropy
B) Increase preload
C) Increase afterload
A. Increase intropy
Which of the following drugs acts to decrease preload?
A) Furosemide
B) Pimobendan
C) Enalapril
D) Digoxin
A. Furosemide
What patient signalment is predisposed to degenerative valve disease?
A) Young, large breed dogs
B) Middle aged to older large breed dogs
C) Middle aged to older small breed dogs
D) Young, small breed dogs
C. Middle aged to older small breeds
You have a long-term patient with stage A degenerative mitral valve disease that you have been diligently monitoring for disease progression.
What is the EARLIEST stage that you should recommend starting cardiac therapies (pimobendan and ACE inhibitor)?
When he progresses to stage B2
A 9 y MC Yorkie presents for evaluation of cough.
A grade IV/VI left apical systolic regurgitant murmur is noted.
Thoracic radiographs reveal a moderately dilated left atrium and mild bronchiolar lung pattern.
What is the most likely diagnosis?
Degenerative mitral valve disease stage B2
A 12 year old spayed female miniature poodle with a history of stage B2 degenerative mitral valve disease presents to your emergency clinic for an acute onset of coughing, increased breathing rates (tachypnea), and an elevated heart rate (tachycardia).
You are concerned that the patient has developed congestive heart failure.
In addition to moderate to severe cardiomegaly, what radiographic findings are expected in a dog with stage C degenerative mitral valve disease?
A) Pleural effusion and/or peritioneal effusion (ascites) and caudal vena cava dilation
B) Interstitial to alveolar pulmonary pattern and pulmonary venous dilation
C) Pleural effusion and/or peritoneal effusion
D) Interstitial to alveolar pulmonary pattern and caudal vena cava dilation
B) Interstitial to alveolar pulmonary pattern and pulmonary venous dilation
Degenerative mitral valve disease is a type of volume overload disease.
What type of ventricular hypertrophy is expected in patients with degenerative mitral valve disease?
Eccentric LV hypertrophy
You are examining a patient with a grade III/VI left apical systolic murmur. Thoracic radiographs show moderate left atrial enlargement, normal pulmonary vessels, and no evidence of pulmonary edema.
What treatments do you recommend for this stage of degenerative mitral valve disease?
A) No cardiac treatments are recommended at this stage
B) Recommend starting Pimobendan and an ACE inhibitor
C) Recommend starting Pimobendan, an ACE inhibitor, and furosemide
D) Recommend starting an ACE inhibitor and furosemide
B) Recommend starting Pimobendan and an ACE inhibitor